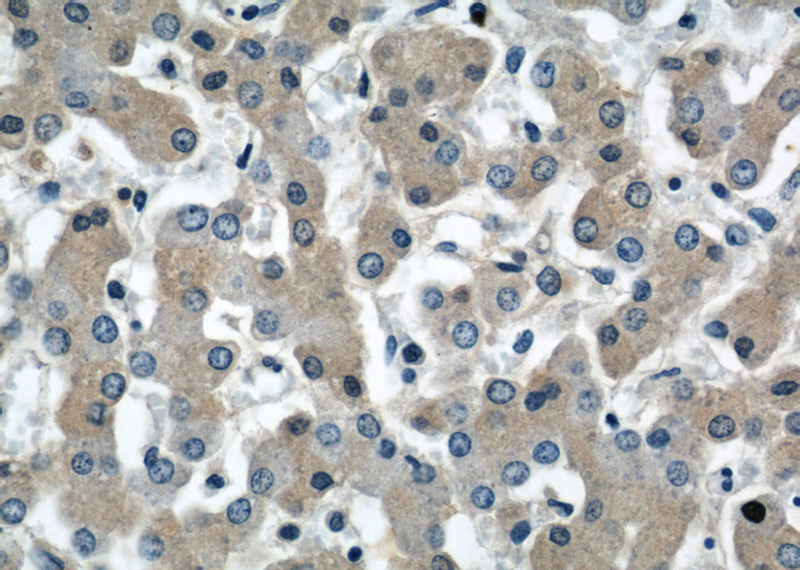
Immunohistochemistry of paraffin-embedded human liver slide using Catalog No:108054(AGT Antibody) at dilution of 1:50

-
Product Name
Angiotensinogen antibody
- Documents
-
Description
Angiotensinogen Rabbit Polyclonal antibody. Positive FC detected in HeLa cells. Positive IHC detected in human liver tissue, human liver cancer tissue. Positive WB detected in HepG2 cells, human plasma tissue. Observed molecular weight by Western-blot: 52-64 kDa
-
Tested applications
ELISA, WB, IHC, FC
-
Species reactivity
Human, Mouse; other species not tested.
-
Alternative names
AGT antibody; Ang I Angiotensin 2 antibody; Ang II Angiotensin 3 antibody; Ang III antibody; Angiotensin I antibody; Angiotensin II antibody; Angiotensin III antibody; Angiotensinogen antibody; ANHU antibody; Des Asp[1] angiotensin II antibody; FLJ92595 antibody; FLJ97926 antibody; Serpin A8 antibody; SERPINA8 antibody
-
Isotype
Rabbit IgG
-
Preparation
This antibody was obtained by immunization of Angiotensinogen recombinant protein (Accession Number: NM_000029). Purification method: Antigen affinity purified.
-
Clonality
Polyclonal
-
Formulation
PBS with 0.1% sodium azide and 50% glycerol pH 7.3.
-
Storage instructions
Store at -20℃. DO NOT ALIQUOT
-
Applications
Recommended Dilution:
WB: 1:200-1:2000
IHC: 1:20-1:200
-
Validations

HepG2 cells were subjected to SDS PAGE followed by western blot with Catalog No:108054(AGT antibody) at dilution of 1:600

Immunohistochemistry of paraffin-embedded human liver slide using Catalog No:108054(AGT Antibody) at dilution of 1:50
Immunohistochemistry of paraffin-embedded human liver slide using Catalog No:108054(AGT Antibody) at dilution of 1:50

1X10^6 HeLa cells were stained with 0.2ug AGT antibody (Catalog No:108054, red) and control antibody (blue). Fixed with 90% MeOH blocked with 3% BSA (30 min). Alexa Fluor 488-congugated AffiniPure Goat Anti-Rabbit IgG(H+L) with dilution 1:1500.
-
Background
Angiotensinogen is a precursor of angiotensin II (Ang II), is expressed and synthesized largely in the liver and is cleaved by the enzyme renin in response to lowered blood pressure. It has a key role in mediating vascular constriction and regulating salt and fluid homeostasis. The resulting product, angiotensin I, is then cleaved by angiotensin converting enzyme (ACE) to generate the physiologically active enzyme angiotensin II. Mutations in this gene are associated with susceptibility to essential hypertension, and can cause renal tubular dysgenesis, a severe disorder of renal tubular development. Defects in this gene have also been associated with non-familial structural atrial fibrillation, and inflammatory bowel disease.
-
References
- Dong YF, Kataoka K, Toyama K. Attenuation of brain damage and cognitive impairment by direct renin inhibition in mice with chronic cerebral hypoperfusion. Hypertension. 58(4):635-42. 2011.
- Lee JS, Lim JY, Kim J. Mechanical stretch induces angiotensinogen expression through PARP1 activation in kidney proximal tubular cells. In vitro cellular & developmental biology. Animal. 51(1):72-8. 2015.
Related Products / Services
Please note: All products are "FOR RESEARCH USE ONLY AND ARE NOT INTENDED FOR DIAGNOSTIC OR THERAPEUTIC USE"
